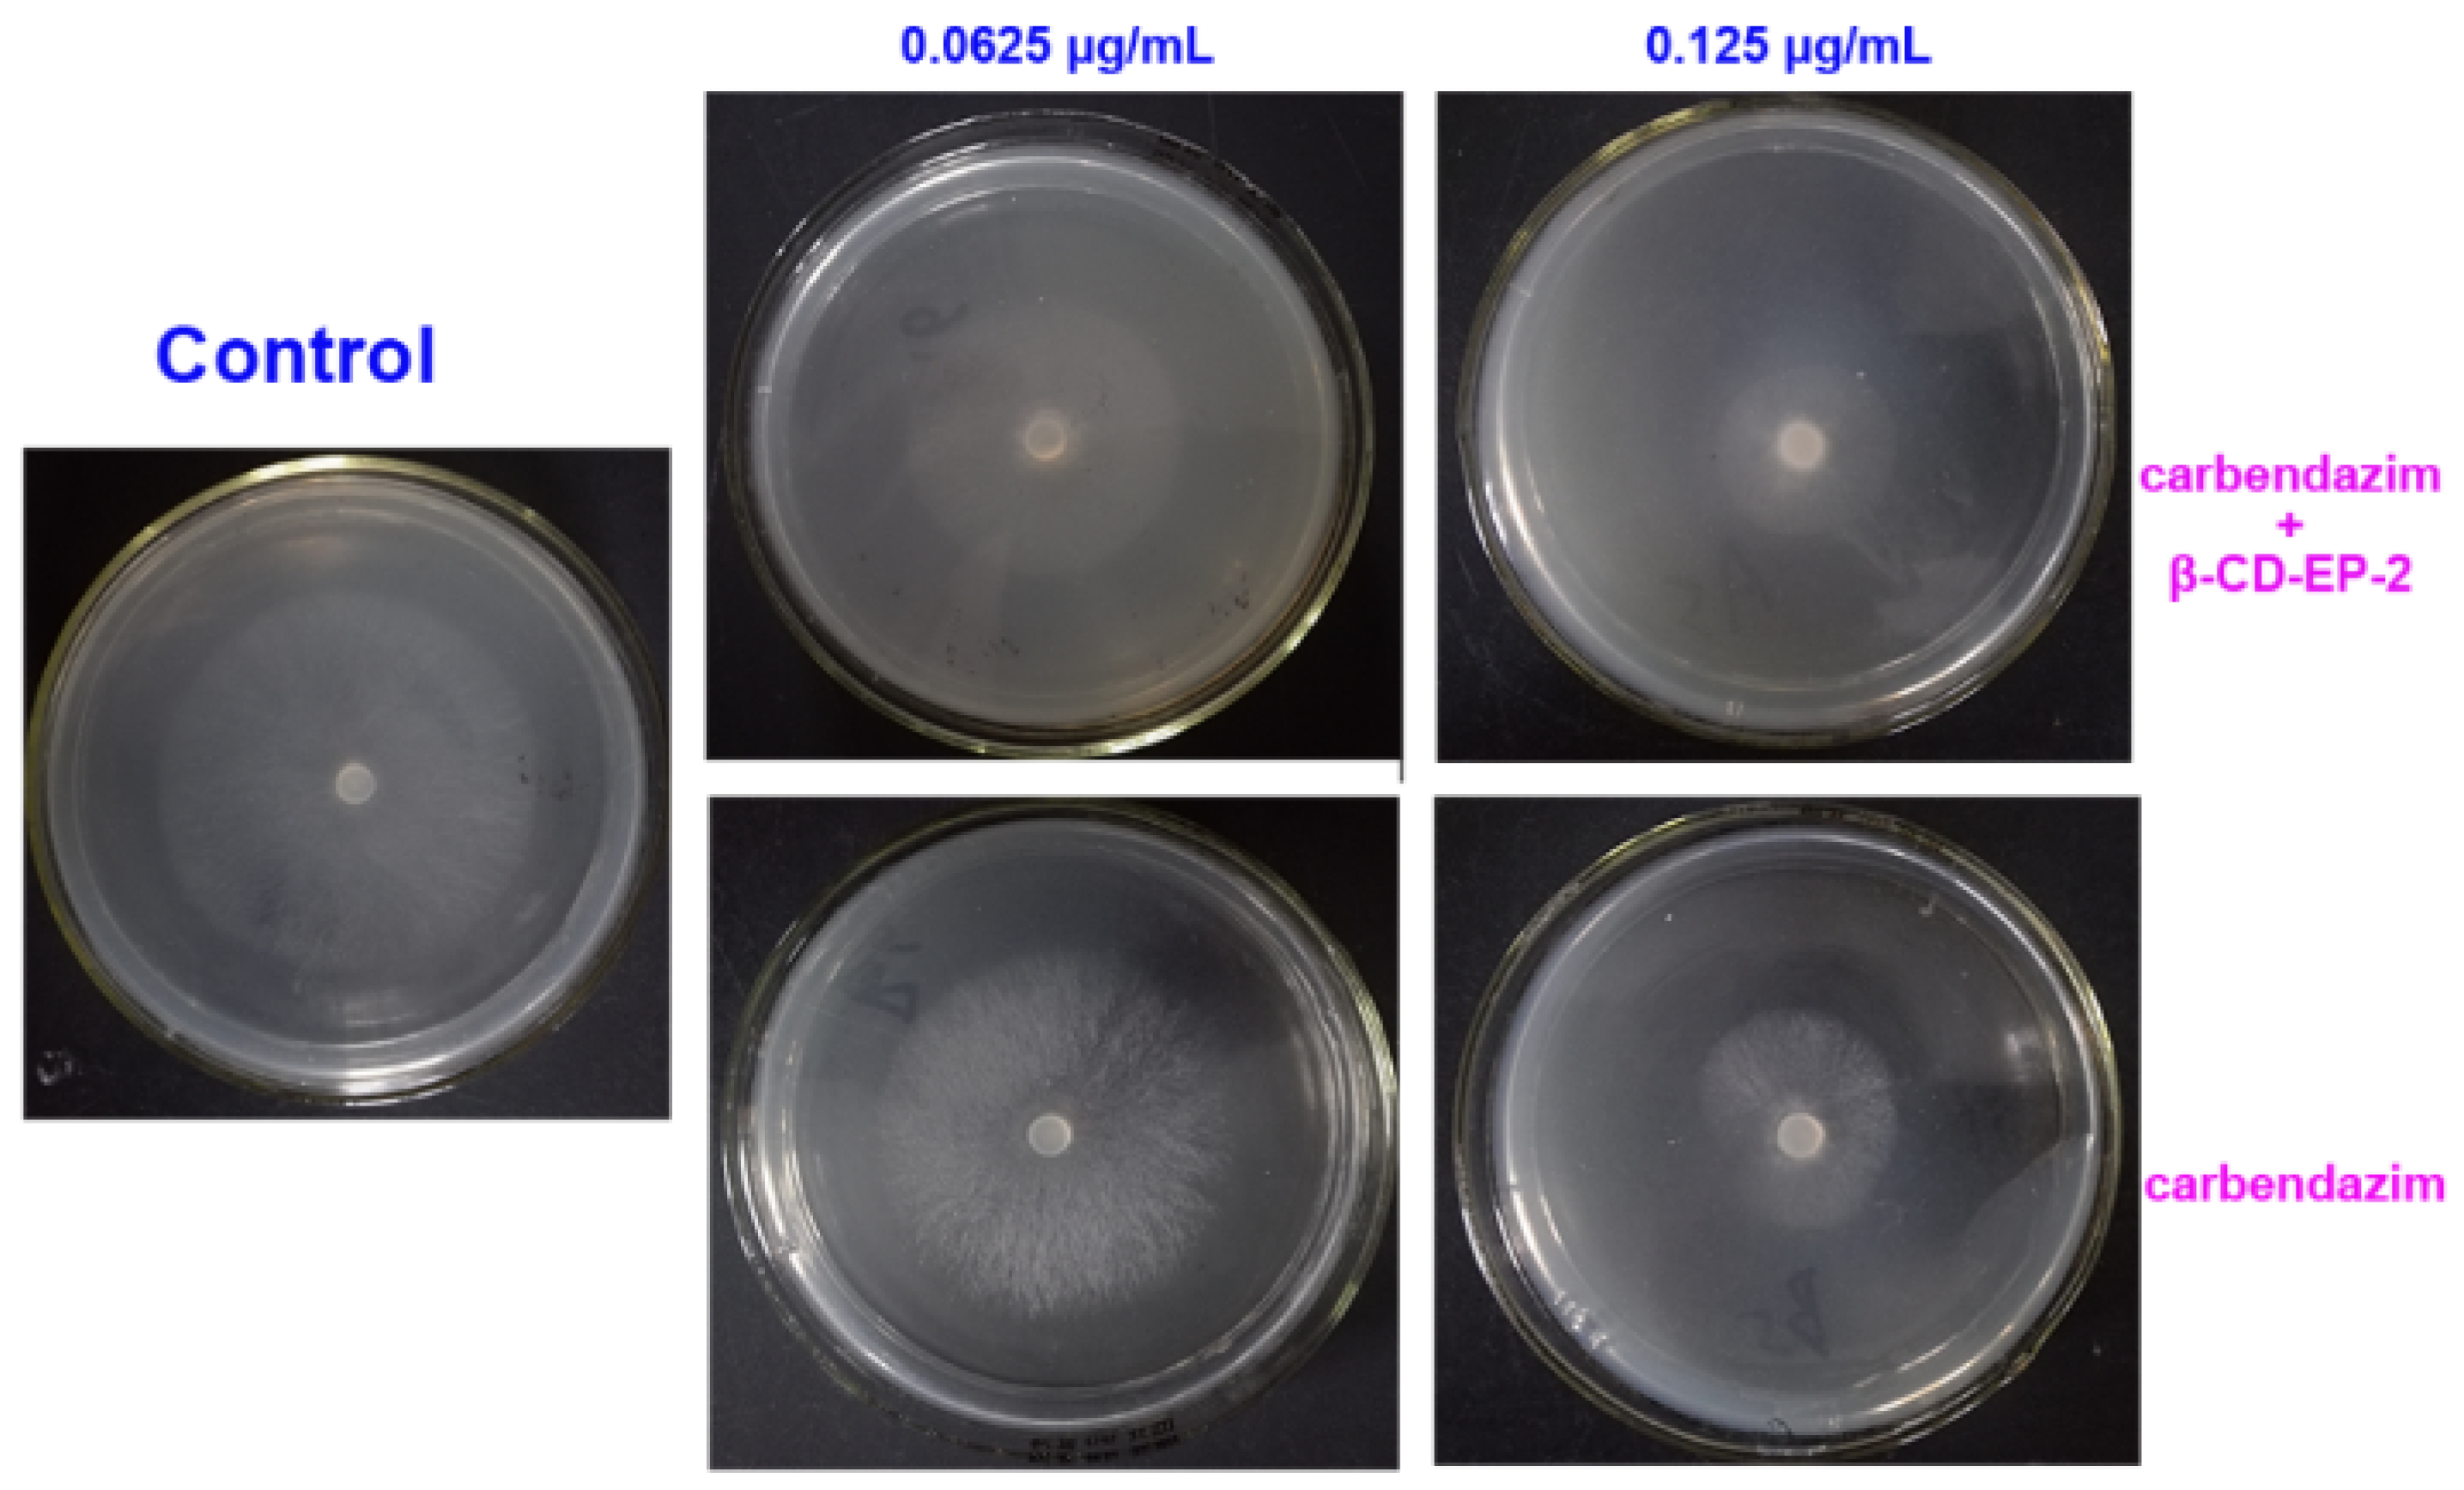
Materials 10 00343 g012
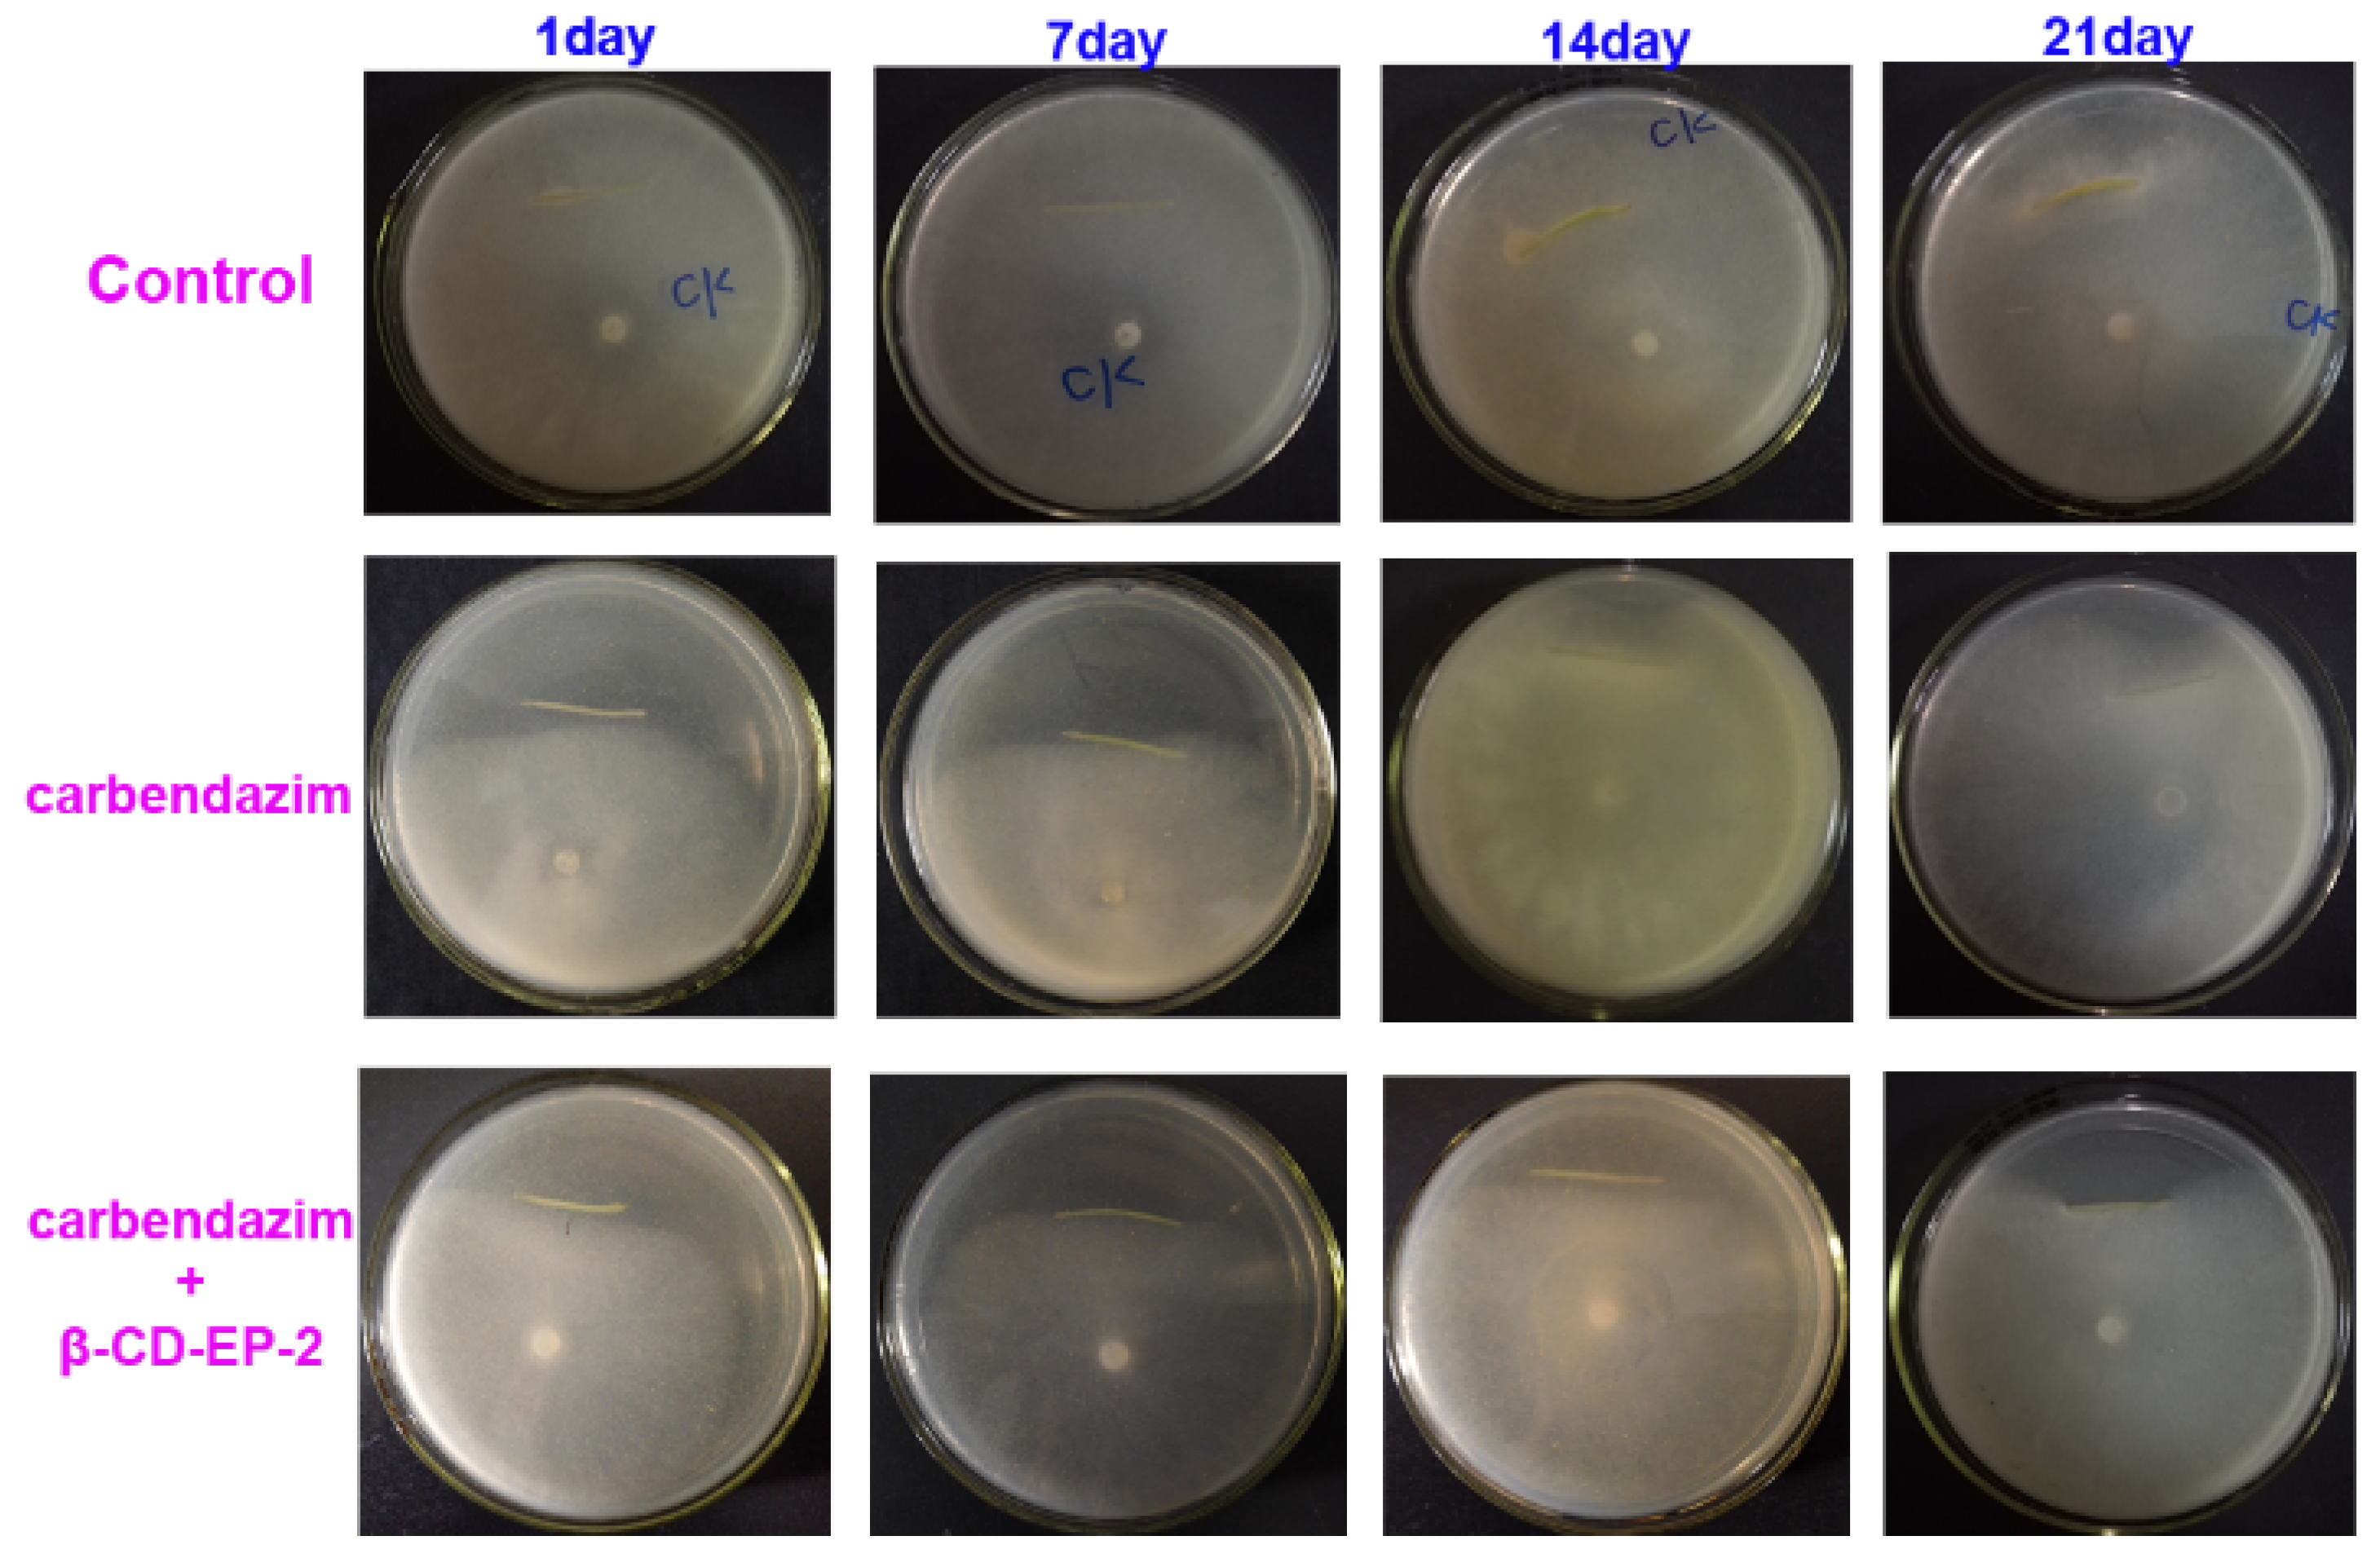
Materials 10 00343 g016

Chitosan and β-Cyclodextrin-epichlorohydrin Polymer Composite Film as a Plant Healthcare Material for Carbendazim-Controlled Release to Protect Rape against Sclerotinia sclerotiorum (Lib.) de Bary
Abstract
:1. Introduction
2. Materials and Methods
2.1. Materials
2.2. Syntheses and Characterizations of β-CD-EP Polymers
2.2.1. Syntheses of β-CD-EP Polymers
2.2.2. Characterizations of β-CD-EP Polymers
2.3. Preparation of β-CD-EP/Carbendazim Complexes
2.4. Interactions between β-CD-EPs and Carbendazim in Solution
2.4.1. Spectrofluorimetric Analysis of Carbendazim
2.4.2. Phase Solubility Studies of β-CD-EP/Carbendazim Complexes
2.4.3. Determination of Complex Stoichiometry
2.5. The In Vitro Antifungal Effects of β-CD-EP/Carbendazim Complexes
2.6. Preparation and Characterization of the Chitosan and β-CD-EP/Carbendazim Composite Films
2.6.1. Preparation of Chitosan and β-CD-EP/Carbendazim Composite Films
2.6.2. Characterization of the Composite Films
2.7. The In Vitro Release Profile of Carbendazim from the Composite Films
2.8. The In Vivo Efficacy of the Composite Films
3. Results and Discussion
3.1. Synthesis and Characterization of β-CD-EP Polymers
3.2. Interactions between β-CD-EP and Carbendazim in Solution
3.2.1. Spectrofluorimetric Analysis of Carbendazim
3.2.2. Phase Solubility Studies of the β-CD-EP/Carbendazim Complexes
3.2.3. Determination of Complex Stoichiometry
3.3. The In Vitro Antifungal Effects of β-CD-EP/Carbendazim Complexes
3.4. Characterization of Chitosan and β-CD-EP/Carbendazim Composite Films
3.5. The In Vitro Release Profile of Carbendazim from the Composite Films
3.6. The In Vivo Efficacy of the Composite Films
4. Conclusions
Acknowledgments
Author Contributions
Conflicts of Interest
References
- Anderson, P.K.; Cunningham, A.A.; Patel, N.G.; Morales, F.J.; Epstein, P.R.; Daszak, P. Emerging infectious diseases of plants: Pathogen pollution, climate change and agrotechnology drivers. Trends Ecol. Evol. 2004, 19, 535–544. [Google Scholar] [CrossRef] [PubMed]
- Fisher, M.C.; Henk, D.A.; Briggs, C.J.; Brownstein, J.S.; Madoff, L.C.; McCraw, S.L.; Gurr, S.J. Emerging fungal threats to animal, plant and ecosystem health. Nature 2012, 484, 186–194. [Google Scholar] [CrossRef] [PubMed]
- Vurro, M.; Bonciani, B.; Vannacci, G. Emerging infectious diseases of crop plants in developing countries: Impact on agriculture and socio-economic consequences. Food Secur. 2010, 2, 113–132. [Google Scholar] [CrossRef]
- Wagacha, J.M.; Muthomi, J.W. Mycotoxin problem in Africa: Current status, implications to food safety and health and possible management strategies. Int. J. Food Microbiol. 2008, 124, 1–12. [Google Scholar] [CrossRef] [PubMed]
- Godfray, H.C.J.; Beddington, J.R.; Crute, I.R.; Haddad, L.; Lawrence, D.; Muir, J.F.; Pretty, J.; Robinson, S.; Thomas, S.M.; Toulmin, C. Food Security: The Challenge of Feeding 9 Billion People. Science 2010, 327, 812. [Google Scholar] [CrossRef] [PubMed]
- Seaman, D. Trends in the formulation of pesticides—An overview. Pestic Sci. 1990, 29, 437–449. [Google Scholar] [CrossRef]
- Longley, M.; Sotherton, N.W. Factors determining the effects of pesticides upon butterflies inhabiting arable farmland. Agric. Ecosyst. Environ. 1997, 61, 1–12. [Google Scholar] [CrossRef]
- de Snoo, G.R.; van der Poll, R.J. Effect of herbicide drift on adjacent boundary vegetation. Agric. Ecosyst. Environ. 1999, 73, 1–6. [Google Scholar] [CrossRef]
- de Snoo, G.R.; de Wit, P.J. Buffer Zones for Reducing Pesticide Drift to Ditches and Risks to Aquatic Organisms. Ecotox Environ. Safe 1998, 41, 112–118. [Google Scholar] [CrossRef] [PubMed]
- Bahadir, M.; Pfister, G. Controlled Release Formulations of Pesticides. In Controlled Release, Biochemical Effects of Pesticides, Inhibition of Plant Pathogenic Fungi; Haug, G., Hoffmann, H., Eds.; Springer: Berlin and Heidelberg, Germany, 1990; pp. 1–64. [Google Scholar]
- Biwer, A.; Antranikian, G.; Heinzle, E. Enzymatic production of cyclodextrins. Appl. Microbiol. Biot. 2002, 59, 609–617. [Google Scholar] [CrossRef] [PubMed]
- Schöffer, J.d.N.; Klein, M.P.; Rodrigues, R.C.; Hertz, P.F. Continuous production of β-cyclodextrin from starch by highly stable cyclodextrin glycosyltransferase immobilized on chitosan. Carbohydr. Polym. 2013, 98, 1311–1316. [Google Scholar] [CrossRef] [PubMed]
- Szejtli, J. Introduction and General Overview of Cyclodextrin Chemistry. Chem. Rev. 1998, 98, 1743–1754. [Google Scholar] [CrossRef] [PubMed]
- Qian, L.; Guan, Y.; Xiao, H. Preparation and characterization of inclusion complexes of a cationic β-cyclodextrin polymer with butylparaben or triclosan. Int. J. Pharm. 2008, 357, 244–251. [Google Scholar] [CrossRef] [PubMed]
- Daoud-Mahammed, S.; Ringard-Lefebvre, C.; Razzouq, N.; Rosilio, V.; Gillet, B.; Couvreur, P.; Amiel, C.; Gref, R. Spontaneous association of hydrophobized dextran and poly-β-cyclodextrin into nanoassemblies.: Formation and interaction with a hydrophobic drug. J. Colloid Interface Sci. 2007, 307, 83–93. [Google Scholar] [CrossRef] [PubMed]
- Nie, S.; Zhang, S.; Pan, W.; Liu, Y. In vitro and in vivo studies on the complexes of glipizide with water-soluble β-cyclodextrin–epichlorohydrin polymers. Drug Dev. Ind. Pharm. 2011, 37, 606–612. [Google Scholar] [CrossRef] [PubMed]
- He, X.; Li, K.; Xing, R.; Liu, S.; Hu, L.; Li, P. The production of fully deacetylated chitosan by compression method. Egypt. J. Aquat. Res. 2016, 42, 75–81. [Google Scholar] [CrossRef]
- Younes, I.; Rinaudo, M. Chitin and Chitosan Preparation from Marine Sources. Structure, Properties and Applications. Mar. Drugs 2015, 13, 1133–1174. [Google Scholar] [CrossRef] [PubMed]
- van de Manakker, F.; Vermonden, T.; van Nostrum, C.F.; Hennink, W.E. Cyclodextrin-Based Polymeric Materials: Synthesis, Properties, and Pharmaceutical/Biomedical Applications. Biomacromolecules 2009, 10, 3157–3175. [Google Scholar] [CrossRef] [PubMed]
- van Haver, E.; Alink, G.M.; Cockburn, A.; Kuiper, H.A.; Peijnenburg, A.A.C.M. Safety and nutritional assessment of GM plants and derived food and feed: The role of animal feeding trials. Food Chem. Toxicol. 2008, 46 (Suppl. S1), S2–S70. [Google Scholar]
- Stephenson, A.L.; Dennis, J.S.; Scott, S.A. Improving the sustainability of the production of biodiesel from oilseed rape in the UK. Process Saf. Environ. Prot. 2008, 86, 427–440. [Google Scholar] [CrossRef]
- Twengström, E.; Sigvald, R.; Svensson, C.; Yuen, J. Forecasting Sclerotinia stem rot in spring sown oilseed rape. Crop Prot 1998, 17, 405–411. [Google Scholar] [CrossRef]
- Peltier, A.J.; Bradley, C.A.; Chilvers, M.I.; Malvick, D.K.; Mueller, D.S.; Wise, K.A.; Esker, P.D. Biology, Yield loss and Control of Sclerotinia Stem Rot of Soybean. J. Integr. Pest Manag. 2012, 3, B1–B7. [Google Scholar] [CrossRef]
- Derbyshire, M.C.; Denton-Giles, M. The control of sclerotinia stem rot on oilseed rape (Brassica napus): Current practices and future opportunities. Plant Pathol. 2016, 65, 859–877. [Google Scholar] [CrossRef]
- Stephen-Haynes, J.; Callaghan, R.; Wibaux, A.; Johnson, P.; Carty, N. Clinical evaluation of a thin absorbent skin adhesive dressing for wound management. J. Wound Care 2014, 23, 532, 534, 536 passim. [Google Scholar] [CrossRef] [PubMed]
- Matsumura, H.; Imai, R.; Ahmatjan, N.; Ida, Y.; Gondo, M.; Shibata, D.; Wanatabe, K. Removal of adhesive wound dressing and its effects on the stratum corneum of the skin: Comparison of eight different adhesive wound dressings. Int. Wound J. 2014, 11, 50–54. [Google Scholar] [CrossRef] [PubMed]
- Quinn, J.; Lowe, L.; Mertz, M. The Effect of a New Tissue-Adhesive Wound Dressing on the Healing of Traumatic Abrasions. Dermatology 2000, 201, 343–346. [Google Scholar] [CrossRef] [PubMed]
- Boateng, J.S.; Matthews, K.H.; Stevens, H.N. E.; Eccleston, G.M. Wound Healing Dressings and Drug Delivery Systems: A Review. J. Pharm. Sci. 2008, 97, 2892–2923. [Google Scholar] [CrossRef] [PubMed]
- Khan, T.A.; Peh, K.K.; Ch'Ng, H.S. Reporting degree of deacetylation values of chitosan: The influence of analytical methods. J. Pharm. Pharm. Sci. 2002, 5, 205–212. [Google Scholar] [PubMed]
- Knaul, J.Z.; Kasaai, M.R.; Bui, V.T.; Creber, K.A.M. Characterization of deacetylated chitosan and chitosan molecular weight review. Can. J. Chem. 1998, 76, 1699–1706. [Google Scholar] [CrossRef]
- Renard, E.; Deratani, A.; Volet, G.; Sebille, B. Preparation and characterization of water soluble high molecular weight β-cyclodextrin-epichlorohydrin polymers. Eur. Polym. J. 1997, 33, 49–57. [Google Scholar] [CrossRef]
- Xin, J.; Guo, Z.; Chen, X.; Jiang, W.; Li, J.; Li, M. Study of branched cationic β-cyclodextrin polymer/indomethacin complex and its release profile from alginate hydrogel. Int. J. Pharm. 2010, 386, 221–228. [Google Scholar] [CrossRef] [PubMed]
- Maddens, T.; Vélaz, I.; Machín, R.; Isasi, J.R.; Martín, C.; Martínez-Ohárriz, M.C.; Zornoza, A. Complexation of ebastine with β-cyclodextrin derivatives. J. Incl. Phenom. Macrocycl. Chem. 2011, 70, 415–419. [Google Scholar] [CrossRef]
- Mura, P.; Faucci, M.T.; Maestrelli, F.; Furlanetto, S.; Pinzauti, S. Characterization of physicochemical properties of naproxen systems with amorphous β-cyclodextrin-epichlorohydrin polymers. J. Pharm. Biomed. Anal. 2002, 29, 1015–1024. [Google Scholar] [CrossRef]
- Higuchi, T.A.; Connors, K.A. Phase-Solubility Techniques. In Advances in Analytical Chemistry and Instrumentation; Interscience: New York, NY, USA, 1965; pp. 117–212. [Google Scholar]
- Job, P. Formation and stability of inorganic complexes in solution. Ann. Chim.-Rome 1928, 9, 113–203. [Google Scholar]
- Renny, J.S.; Tomasevich, L.L.; Tallmadge, E.H.; Collum, D.B. Method of Continuous Variations: Applications of Job Plots to the Study of Molecular Associations in Organometallic Chemistry. Angew. Chem. Int. Edit. 2013, 52, 11998–12013. [Google Scholar] [CrossRef] [PubMed]
- Zhu, X.-L.; Wang, H.-B.; Chen, Q.; Yang, W.-C.; Yang, G.-F. Preparation and Characterization of Inclusion Complex of Iprodione and β-Cyclodextrin to Improve Fungicidal Activity. J. Agric. Food Chem. 2007, 55, 3535–3539. [Google Scholar] [CrossRef] [PubMed]
- Sainz-Rozas, P.R.; Isasi, J.R.; González-Gaitano, G. Binding of dibenzofuran and its derivatives to water-soluble β-cyclodextrin polymers. J. Photochem. Photobiol. A: Chem. 2005, 173, 248–257. [Google Scholar] [CrossRef]
- Gómez-Galván, F.; Pérez-Álvarez, L.; Matas, J.; Álvarez-Bautista, A.; Poejo, J.; Duarte, C.M.; Ruiz-Rubio, L.; Vila-Vilela, J.L.; León, L.M. Preparation and characterization of soluble branched ionic β-cyclodextrins and their inclusion complexes with triclosan. Carbohydr. Polym. 2016, 142, 149–157. [Google Scholar] [CrossRef] [PubMed]
- Ao, X.; Stenken, J.A. Water-soluble cyclodextrin polymers for enhanced relative recovery of hydrophobic analytes during microdialysis sampling. Analyst 2003, 128, 1143–1149. [Google Scholar] [CrossRef] [PubMed]
- Pham, T.A.; Kumar, N.A.; Jeong, Y.T. Covalent functionalization of graphene oxide with polyglycerol and their use as templates for anchoring magnetic nanoparticles. Synth. Met. 2010, 160, 2028–2036. [Google Scholar] [CrossRef]
- Abdel-Shafi, A.A. Inclusion complex of 2-naphthylamine-6-sulfonate with β-cyclodextrin: Intramolecular charge transfer versus hydrogen bonding effects. Spectrochim. Acta A: Mol. Biomol. Spectrosc. 2007, 66, 1228–1236. [Google Scholar] [CrossRef] [PubMed]
- Du, X.Z.; Zhang, Y.; Jiang, Y.B.; Huang, X.Z.; Chen, G.Z. Study of room-temperature phosphorescence of 1-bromonaphthalene in sodium dodecylbenzene sulfonate and β-cyclodextrin solution. Spectrochim. Acta A: Mol. Biomol. Spectrosc. 1997, 53, 671–677. [Google Scholar] [CrossRef]
- Boldescu, V.; Macaev, F.; Duca, G. Role of cyclodextrins in new antimycobacterial formulations. Chem. J. Mold. 2014, 9, 8–13. [Google Scholar]
- Fliur, M.; Veaceslav, B.; Athina, G.; Natalia, S. Recent Advances in the Use of Cyclodextrins in Antifungal Formulations. Curr. Top. Med. Chem. 2013, 13, 2677–2683. [Google Scholar]
- Huang, Z.; London, E. Effect of Cyclodextrin and Membrane Lipid Structure upon Cyclodextrin–Lipid Interaction. Langmuir 2013, 29, 14631–14638. [Google Scholar] [CrossRef] [PubMed]
- Croisier, F.; Jérôme, C. Chitosan-based biomaterials for tissue engineering. Eur. Polym. J. 2013, 49, 780–792. [Google Scholar] [CrossRef]
- Luciano, N.M.; Ignacio, M.H.; Julio, A.L. Recent Advances in Chitosan Films for Controlled Release of Drugs. Recent Patents Drug Deliv. Formul. 2012, 6, 156–170. [Google Scholar]
- Elsabee, M.Z.; Abdou, E.S. Chitosan based edible films and coatings: A review. Mater. Sci. Eng.: C 2013, 33, 1819–1841. [Google Scholar] [CrossRef] [PubMed]
- Aider, M. Chitosan application for active bio-based films production and potential in the food industry: Review. LWT—Food Sci. Technol. 2010, 43, 837–842. [Google Scholar] [CrossRef]
- Costa, P.; Sousa Lobo, J.M. Modeling and comparison of dissolution profiles. Eur. J. Pharm. Sci. 2001, 13, 123–133. [Google Scholar] [CrossRef]
- Arifin, D.Y.; Lee, L.Y.; Wang, C.-H. Mathematical modeling and simulation of drug release from microspheres: Implications to drug delivery systems. Adv. Drug Deliv. Rev. 2006, 58, 1274–1325. [Google Scholar] [CrossRef] [PubMed]
- Bai, C.; Zhang, S.; Huang, L.; Wang, H.; Wang, W.; Ye, Q. Starch-based hydrogel loading with carbendazim for controlled-release and water absorption. Carbohydr. Polym. 2015, 125, 376–383. [Google Scholar] [CrossRef] [PubMed]
- Sandhya; Kumar, S.; Kumar, D.; Dilbaghi, N. Preparation, characterization, and bio-efficacy evaluation of controlled release carbendazim-loaded polymeric nanoparticles. Environ. Sci. Pollut. Res. 2017, 24, 926–937. [Google Scholar] [CrossRef] [PubMed]
- Campos, E.V.R.; Oliveira, J.L.D.; da Silva, C.M.G.; Pascoli, M.; Pasquoto, T.; Lima, R.; Abhilash, P.C.; Fernandes Fraceto, L. Polymeric and Solid Lipid Nanoparticles for Sustained Release of Carbendazim and Tebuconazole in Agricultural Applications. Sci. Rep. 2015, 5, 13809. [Google Scholar] [CrossRef] [PubMed]
- Sangalli, M.E.; Zema, L.; Maroni, A.; Foppoli, A.; Giordano, F.; Gazzaniga, A. Influence of betacyclodextrin on the release of poorly soluble drugs from inert and hydrophilic heterogeneous polymeric matrices. Biomaterials 2001, 22, 2647–2651. [Google Scholar] [CrossRef]
- Buschmann, H.-J.; Schollmeyer, E. Applications of cyclodextrins in cosmetic products: A review. J. Cosmet. Sci. 2002, 53, 185–191. [Google Scholar] [PubMed]
- Del Valle, E.M.M. Cyclodextrins and their uses: A review. Process Biochem. 2004, 39, 1033–1046. [Google Scholar] [CrossRef]

| Sample | EP/β-CD (Molar Ratio) | Time of Gelation (h) | β-CD Content (mg/g) | Hydrodynamic Diameter (nm) | Solubility (g/100 mL) |
|---|---|---|---|---|---|
| β-CD-EP-1 | 8/1 | - | 750 | 5.2 ± 0.5 | 35.4 ± 1.6 |
| β-CD-EP-2 | 15/1 | - | 440 | 8.3 ± 1.3 | 42.3 ± 1.5 |
| β-CD-EP-3 | 17/1 | 2 h | - | - | - |
| Sample | Slope | r2 | Ks (M−1) | Solubilizing Efficiency | LE (%) |
|---|---|---|---|---|---|
| β-CD-EP-1 | 0.01197 | 0.9965 | 330.1 | 17.9 ± 0.2 | 27.4 ± 2.1 |
| β-CD-EP-2 | 0.01214 | 0.9997 | 334.8 | 18.5 ± 0.3 | 31.2 ± 1.6 |
| System | Toxicity Regression Equation | Correlation Coefficient (r) | EC50 (μg/mL) | Synergistic Times |
|---|---|---|---|---|
| carbendazim | y = 8.397 + 3.438x | 0.9928 | 0.103 | - |
| β-CD-EP-2/carbendazim | y = 8.695 + 3.508x | 0.9959 | 0.0885 | 1.16 |
| System | The Mycelial Growth Inhibition Rates (%) | ||||
|---|---|---|---|---|---|
| 1 day | 7 days | 14 days | 21 days | 28 days | |
| carbendazim | 100 | 100 | 52.7 ± 3.4 | 28.2 ± 9.5 | - |
| β-CD-EP-2/carbendazim | 100 | 100 | 100 | 100 | 49.4 ± 5.6 |
© 2017 by the authors. Licensee MDPI, Basel, Switzerland. This article is an open access article distributed under the terms and conditions of the Creative Commons Attribution (CC BY) license (http://creativecommons.org/licenses/by/4.0/).
Share and Cite
Wang, D.; Jia, M.; Wang, L.; Song, S.; Feng, J.; Zhang, X. Chitosan and β-Cyclodextrin-epichlorohydrin Polymer Composite Film as a Plant Healthcare Material for Carbendazim-Controlled Release to Protect Rape against Sclerotinia sclerotiorum (Lib.) de Bary. Materials 2017, 10, 343. https://doi.org/10.3390/ma10040343
Wang D, Jia M, Wang L, Song S, Feng J, Zhang X. Chitosan and β-Cyclodextrin-epichlorohydrin Polymer Composite Film as a Plant Healthcare Material for Carbendazim-Controlled Release to Protect Rape against Sclerotinia sclerotiorum (Lib.) de Bary. Materials. 2017; 10(4):343. https://doi.org/10.3390/ma10040343
Chicago/Turabian StyleWang, Delong, Mingchen Jia, Lanying Wang, Shuang Song, Juntao Feng, and Xing Zhang. 2017. "Chitosan and β-Cyclodextrin-epichlorohydrin Polymer Composite Film as a Plant Healthcare Material for Carbendazim-Controlled Release to Protect Rape against Sclerotinia sclerotiorum (Lib.) de Bary" Materials 10, no. 4: 343. https://doi.org/10.3390/ma10040343
APA StyleWang, D., Jia, M., Wang, L., Song, S., Feng, J., & Zhang, X. (2017). Chitosan and β-Cyclodextrin-epichlorohydrin Polymer Composite Film as a Plant Healthcare Material for Carbendazim-Controlled Release to Protect Rape against Sclerotinia sclerotiorum (Lib.) de Bary. Materials, 10(4), 343. https://doi.org/10.3390/ma10040343







